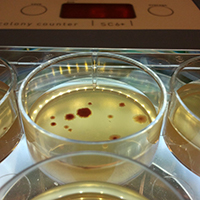

Keele strikes Gold in the Teaching Excellence Framework
Posted on 21 June 2017 Keele University has been awarded Gold in the Teaching Excellence Framework (TEF)
2017: A Year in the News
Posted on 20 December 2017 As we come to the end of another successful year at Keele, here are some of our highlights from 2017
New University halls welcomes first residents
Posted on 22 December 2017 Over 450 students at Keele University are moving into their new halls of residence this week.
We're volcano scientists – here are six volcanoes we'll be watching out for in 2018
Posted on 02 January 2018 Ralf Gertisser, Senior Lecturer in Mineralogy and Petrology, Keele University; Katie Preece, Research Associate in Volcanology, University of Glasgow, and Sylvain Charbonnier, Assistant Professor in Volcanology, University of South Florida write for The Conversation UK
Keele in top ten for on-campus Wi-Fi
Posted on 19 December 2017 Keele University has been ranked in the top ten for Wi-Fi on its campus, according to data based on student reviews.
Keele academic wins ‘Most Innovative Teacher of the Year’ award!
Posted on 01 December 2017 Dr Russell Crawford is the winner of the prestigious ‘Most Innovative Teacher of the Year’ award at the national Times Higher Education Awards 2017.
Christmas earworms: the science behind our love-hate relationship with festive songs
Posted on 18 December 2017 Alexandra Lamont, Senior Lecturer in Music Psychology writes for The Conversation UK
Why Hollywood needs more films like Star Wars
Posted on 13 December 2017 Neil Archer, Lecturer in Film Studies writes for The Conversation UK
Keele professor appointed President of the Association of Cancer Surgery
Posted on 06 December 2017 Keele University’s Robert Kirby, Professor of Clinical Education and Surgery, and Dean of the University Hospitals of North Midlands (UHNM), has been appointed President of the British Association of Surgical Oncology (BASO).
Stoke-on-Trent’s Cultural Observatory announces plans to measure the impact of UK City of Culture 2021
Posted on 05 December 2017 The Cultural Observatory – established by Staffordshire and Keele Universities – will play a lead role in evaluating the powerful impact that a year-long festival of culture will have on the city and its people
Why remote Antarctica is so important in a warming world
Posted on 04 December 2017 Chris Fogwill, Professor of Glaciology and Palaeoclimatology, Keele University; Chris Turney, Professor of Earth Sciences and Climate Change, UNSW, and Zoe Robinson, Reader in Physical Geography and Sustainability/Director of Education for Sustainability, Keele University write for The Conversation UK
Selling homes for £1 gives local authorities the power to revive deprived communities
Posted on 04 December 2017 Ian Mahoney, Lecturer in Criminology, Liverpool Hope University and Tony Kearon, Senior Lecturer in Criminology, Co-Director of the Keele Policing Academic Collaboration (KPAC), Keele University write for The Conversation UK
Keele ranked No. 1 in England for Course Satisfaction
Posted on 01 June 2017 Keele University is the number one institution in England for Course Satisfaction, according to the Guardian University Guide 2018.
Ol' Man River – how gendered language shapes the way we see the world
Posted on 29 November 2017 Ella Tennant, Acting Programme Director for Liberal Arts writes for The Conversation UK
Why revolutionary Russia backed Turkish nationalists over communists
Posted on 28 November 2017 Bulent Gökay, Professor of International Relations writes for The Conversation UK
Keele graduate is a finalist at Study UK Alumni Awards
Posted on 27 November 2017 Keele graduate Professor Weiwei Cao has been announced as a finalist at the prestigious British Council Study UK Alumni Awards 2017-18
Here’s what the science says about animal sentience
Posted on 24 November 2017 Jan Hoole, Lecturer in Biology writes for The Conversation UK
Keele University launches the Children and Young People’s Research Network
Posted on 20 November 2017 The Children and Young People’s Research Network will focus on promoting and protecting the rights of the child
Keele Vice-Chancellor furthers role as knowledge exchange champion
Posted on 16 November 2017 Keele University Vice-Chancellor Professor Trevor McMillan has been invited to attend the newly-formed Research England Council board meetings, in order to help deliver the Council’s aim to create and sustain the conditions for a healthy and dynamic research and knowledge exchange system in English universities.
New dye gives scientists a clearer insight into the brain
Posted on 16 November 2017 Keele University researchers have designed a new dye that can be used to observe the electrical activity of neurons in the brain and could lead to finding a new and more efficient way of treating neurological diseases, as presented at the prestigious Society for Neuroscience annual conference in Washington, D.C. this week.
The good news about plastic waste
Posted on 15 November 2017 Deirdre McKay, Senior Lecturer in Geography writes for The Conversation UK
Keele’s Head of Pharmacy presents guest lecture
Posted on 13 November 2017 Professor Nigel Ratcliffe, Head of the School of Pharmacy at Keele, spoke on the future of the pharmaceutical industry at the University of Sunderland’s annual pharmacy lecture last week.
Keele University and B-Arts to host event for national humanities festival
Posted on 09 November 2017 Keele University, with community partner B-Arts, is hosting ‘Play with Plastics’, an event in Being Human 2017, the UK’s only national festival of the humanities.
Keele University is a Leading Places pilot area
Posted on 09 November 2017 Keele University and local partners have been chosen by the Local Government Association (LGA), the Higher Education Funding Council for England (HEFCE), and Universities UK (UUK) to be a Leading Places pilot area.
Rare treatment for arthritis wins NHS approval
Posted on 20 October 2017 A rare treatment for a type of arthritis in the knee performed by a Keele professor has gained official approval to be funded by the NHS.
How to solve the 'monster' fatberg problem
Posted on 06 November 2017 Alison Browne, Lecturer in Human Geography and the Sustainable Consumption Institute, University of Manchester and Mike Foden, Postdoctoral Research Associate, Keele University write for The Conversation UK
Keele pledges to Go International: Stand Out!
Posted on 02 November 2017 Keele University has signed the Universities UK International (UUKi) pledge to increase opportunities for students to study, work or volunteer overseas.
Keele and Oxford top table for producing most psychiatrists
Posted on 26 October 2017 Keele University has been ranked joint first with the University of Oxford for producing the most psychiatrists of any medical school in England.
Big cats in Britain: urban myth or scientific fact?
Posted on 02 November 2017 Jan Hoole, Lecturer in Biology writes for The Conversation UK
Forget The Apprentice, where are all the young entrepreneurs?
Posted on 27 October 2017 Udeni Salmon, Research Associate, Keele University writes for The Conversation UK
Keele leads review of social media use by GP surgeries
Posted on 25 October 2017 A review of social media use by GP surgeries has revealed the potential dangers of un-moderated, unofficial Facebook pages.
Keele wins HEFCE funding to expand Active Bystanders campaign
Posted on 18 October 2017 Keele University has been awarded funding from the Higher Education Funding Council for England (HEFCE) to develop a comprehensive safeguarding toolkit and secure reporting mechanism for hate incidents and online harassment.
Are dogs trying to tell us something with their expressions?
Posted on 19 October 2017 Jan Hoole, Lecturer in Biology writes for The Conversation UK
Keele students donate three tonnes of food to local foodbank
Posted on 11 October 2017 Generous Keele University students have donated three tonnes of food to Newcastle-Staffs Foodbank.
Alcohol Impact Accreditation for Keele University and Keele Students’ Union
Posted on 17 October 2017 Keele University and Keele Students’ Union have officially received the Alcohol Impact Accreditation
HEFCE funds new Keele Health Apprenticeships Hub
Posted on 05 October 2017 Keele University has secured £82,000 from the HEFCE Degree Apprenticeships Development Fund to establish the Keele Health Apprenticeships hub
Keele academic helps design new road safety device
Posted on 17 October 2017 A Keele University criminologist has contributed to the design of a new road safety device that detects the use of a mobile phone in a moving vehicle.
RCUK funding will enrich public engagement at Keele University
Posted on 09 October 2017 Research Councils UK (RCUK) has announced the launch of the Strategic Support to Expedite Embedding Public Engagement with Research (SEE-PER) grants.
Keele schools receive bronze Athena SWAN award
Posted on 06 October 2017 Keele University’s School of Law and School of Pharmacy have been successful in achieving an Athena SWAN Bronze award.
Staffordshire and Keele Universities join forces to create a Cultural Observatory
Posted on 29 September 2017 Staffordshire and Keele Universities have come together to establish a Cultural Observatory which will play a leading role in Stoke-on-Trent’s bid to be UK City of Culture in 2021.
Philip K Dick: you may not have read his books, but you've almost certainly seen the movies
Posted on 06 October 2017 Dr James Peacock, Senior Lecturer in English and American Literatures, writes for The Conversation
Keele celebrates research centre’s 25th anniversary
Posted on 03 October 2017 Keele University’s Faculty of Natural Sciences held a range of celebrations last week to mark the 25th anniversary of the the Centre for Applied Entomology and Parasitology (CAEP).
Star Trek Discovery: diverse futuristic vision let down by 20th-century gender stereotypes
Posted on 04 October 2017 Gene Roddenberry's vision has been upheld by diverse casting, but storylines remain within mainstream 20th-century ideas of gender and identity
How to avoid war and conflict – with a little help from social psychology
Posted on 05 October 2017 There are methods to avoid madness
‘Most Innovative Teacher’ nomination for inspirational Keele academic
Posted on 07 September 2017 Dr Russell Crawford has been shortlisted in the prestigious ‘Most Innovative Teacher of the Year’ category at the national Times Higher Education Awards 2017.
What if the AfD’s 12.6% is a fair price to pay for German democracy?
Posted on 28 September 2017 Aristotle Kallis, Professor of Modern and Contemporary History writes for The Conversation UK
Kurdistan: after vote for independence, what’s next?
Posted on 27 September 2017 Rebecca Richards, Keele University and Robert Smith, Coventry University write for The Conversation UK
In sickness and in health: fourfold increase in likelihood of seeing your doctor about anxiety or depression if your partner has already done so
Posted on 25 September 2017 A study led by Keele University has found that when one partner of a couple consults their GP about depression or anxiety, the other partner is much more likely to do the same.
Ancient tree reveals cause of spike in Arctic temperature
Posted on 12 September 2017 Study led by scientists from Keele University and UNSW Sydney provides fresh insights into the mechanisms of climate change
My favourite album: David Bowie’s Diamond Dogs
Posted on 25 September 2017 Alex Sharpe, Professor of Law writes for The Conversation UK
How animals vote to make group decisions
Posted on 18 September 2017 Jan Hoole, Lecturer in Biology writes for The Conversation UK
Who should pay for damage associated with climate change – and who should be compensated?
Posted on 18 September 2017 John Vogler and Marit Hammond write for The Conversation UK
Using AI to determine queer sexuality is misconceived and dangerous
Posted on 15 September 2017 Alex Sharpe, Professor of Law and Senthorun Raj, Lecturer, Keele Law School write for The Conversation UK
Award-winning broadcaster speaks to packed audience at Keele
Posted on 05 September 2017 Samira, who presents Front Row on BBC Radio 4 and Newswatch on BBC1, gave a free public lecture entitled “What Can Arnold Bennett Teach Brexit Britain”
Eating oily fish during pregnancy could prevent schizophrenia in the child, new study suggests
Posted on 07 September 2017 David Mazzocchi-Jones, Lecturer in Neurosciencewrites for The Conversation UK
Keele Professor awarded major grant to investigate lives of those touched by Old Poor Law
Posted on 05 September 2017 Professor Alannah Tomkins has been awarded an AHRC grant of £728k to investigate the lives of thousands of people who benefited from the Old Poor Law
A social psychologist explains how authorities can regain survivors’ trust after Grenfell Tower fire
Posted on 01 September 2017 Ken Rotenberg, Professor in Psychology writes for The Conversation (UK)
Violent evictions of refugees in Rome reveal inhumanity of modern democracy
Posted on 30 August 2017 Mariangela Palladino, Lecturer in Postcolonial Studies writes for The Conversation (UK)
Keele works with Manchester University on major antibiotic resistance research
Posted on 25 August 2017 Researchers at Keele University have contributed to a major study on antibiotic resistance, led by The University of Manchester.
Improving the recognition of anxiety and depression in rheumatoid arthritis
Posted on 24 August 2017 A study conducted by Keele University shows that patients with rheumatoid arthritis who are also suffering with anxiety or depression may avoid talking to their GP about their mental health symptoms.
Keele student to make a splash for Team GB
Posted on 15 August 2017 A student from Keele University has been chosen to represent Team GB at the World University Games taking place in Chinese Taipei this summer.
Little prospect of regime change in Russia short of a popular uprising – and that's unlikely
Posted on 18 August 2017 Matthew Wyman writes for The Conversation (UK).
Keele University invests £45m in STEM facilities
Posted on 26 June 2017 Keele University is investing £45m in the creation of new state-of-the-art science facilities
Award-winning journalist visits Keele to discuss Bennett and Brexit
Posted on 15 August 2017 Keele University will welcome journalist and broadcaster Samira Ahmed onto its campus in September to explore how local novelist Arnold Bennett speaks to modern Britain.
The German Great Escape: the science of how 83 military officers tunnelled out of Welsh prison in 1945
Posted on 09 August 2017 Jamie Pringle, Senior Lecturer in Engineering & Environmental Geosciences writes for The Conversation (UK).
Keele helps University of Cambridge find smallest-ever star
Posted on 12 July 2017 Stars like our Sun are much bigger than planets but now a star has been found that is only the size of the planet Saturn.
Minister of State for Climate Change and Industry visits Keele
Posted on 07 July 2017 Claire Perry, Minister of State for Climate Change and Industry visited Keele on Friday for a roundtable discussion on energy and environmental research.
MoU for development of new joint Veterinary School
Posted on 20 July 2017 Keele and Harper Adams sign MoU for development of new joint Veterinary School
The real Quacks: medical misadventures in the Victorian era
Posted on 16 August 2017 Professor Alannah Tomkins writes for The Conversation (UK).
Beware the border patrol: the nasty history of airport discrimination
Posted on 14 August 2017 Rachel Bright, Lecturer in Modern History writes for The Conversation (UK)
Venezuela crisis is the hidden consequence of Saudi Arabia’s oil price war
Posted on 08 August 2017 Bulent Gökay, Professor of International Relations, writes for The Conversation UK
Retail banks are on a charm offensive – but mis-selling continues
Posted on 08 August 2017 Matthew J Brannan, Lecturer in Management, writes for The Conversation UK
Study confirms obese people have better survival rates following heart procedure
Posted on 02 August 2017 Research has confirmed that overweight people undergoing coronary heart procedure are more likely to survive and have fewer complications compared to patients with a healthy weight.
How does a country become a country? An expert explains
Posted on 03 August 2017 Rebecca Richards, Lecturer in International Relations writes for The Conversation
Young students search for eclipsing star systems at Keele University
Posted on 13 July 2017 Twenty local students visited Keele University last week to take part in an astrophysics research project.
Big-headed gecko shows human actions are messing with evolution
Posted on 26 July 2017 New research shows that a type of lizard living on man-made islands in Brazil has developed a larger head than its mainland cousins in a period of only 15 years.
Students inspired at summer writing camps
Posted on 26 July 2017 Students from five high schools in Staffordshire and Cheshire have had the opportunity to write and publish their own novels
High Sheriff of Staffordshire visits Keele, his ancestral family home
Posted on 27 July 2017 Humphrey David Sneyd Scott-Moncrieff DL, the current High Sheriff of Staffordshire, recently paid a visit to Keele University and enjoyed a tour of his ancestral family home, Keele Hall.
Against The Law review: a fitting tribute to gay men whose persecution in 1950s paved way for new rights
Posted on 27 July 2017 Dominc Janes, Professor of Modern History, writes for The Conversation UK about the BBC2 film 'Against the Law'
New Hot Jupiter marks the first collaborative exoplanet discovery
Posted on 18 July 2017 Researchers led by a team at Keele University have discovered a new ‘Hot Jupiter’ exoplanet.
On sexuality, the law still caters to the norms of public disgust
Posted on 25 July 2017 Law is an emotional creature, animated by visceral human feelings
Girls in Maths
Posted on 24 July 2017 Over 130 students and their teachers from ten schools visited Keele University recently for a Maths outreach and enrichment event.
Keele alumnus appointed to Court of Appeal
Posted on 24 July 2017 Her Majesty The Queen has approved the appointment of one Lady Justice and six Lord Justices of Appeal, including Keele alumnus Sir Peter Coulson.
Keele becomes one of the first universities awarded a meningitis awareness mark
Posted on 01 August 2017 Keele University has signed up to the UK’s first Meningitis Aware Recognition Mark (MARM) for Universities, developed by charity Meningitis Now.
Stoke-on-Trent named as UK City of Culture 2021 finalist
Posted on 18 July 2017 Stoke-on-Trent has been shortlisted as a finalist for UK City of Culture 2021
Honorary Graduates Dr Catherine Raines and Joyce D'Silva
Posted on 13 July 2017 In recognition of their outstanding contributions to society, both globally and within the UK, Dr Catherine Raines and Joyce D’Silva have been awarded Honorary Degrees.
Honorary Graduate Joseph Clarke MBE
Posted on 12 July 2017 In recognition of his inspirational self-determination to achieve his personal ambitions as an Olympian, Joe Clarke, MBE has been awarded Master of the University at Keele University.
Student of the Year 2017
Posted on 10 July 2017 Keele University is delighted to announce the twelfth Neil and Gina Smith Student of the Year Award.
Do cats purr when humans aren’t around?
Posted on 03 July 2017 Dr Janet Hoole, Lecturer in Biology, writes for The Conversation.
Students inspired at Potteries Science Festival
Posted on 10 July 2017 Students from across Stoke-on-Trent enjoyed an evening of scientific inspiration as part of the Potteries Science Festival
Atmosphere detected around an Earth-like planet
Posted on 28 April 2017 Astronomers at Keele University have detected an atmosphere around the super-Earth planet GJ 1132b
Keele University to become Europe’s largest Smart Energy Network Demonstrator
Posted on 30 November 2016 £15 million investment will create the first facility in Europe for at-scale living laboratory research, development and demonstration.
Swearing helps us battle pain – no matter what language we curse in
Posted on 13 December 2017 Olly Robertson, PhD Candidate in Psychology writes for The Conversation UK
Keele University brings back prestigious Roy Fisher Prize for Poetry
Posted on 30 November 2017 Creative writers from across Staffordshire are being encouraged to submit examples of their poetry for a chance to see their work published.
Q&A with Ralph Findlay, Chair of Council at Keele University 2014-2018
Posted on 29 November 2017 Q & A with Ralph Findlay, Chair of Council at Keele University 2014-2018
What does 'Orwellian' mean, anyway?
Posted on 21 November 2017 Boris Johnson and Michael Gove may not be the stuff of Orwell's dystopian nightmare, but they clearly know how to talk in 'doublespeak'. Dr Nick Bentley writes for The Conversation UK
Heart failure more fatal than common cancers
Posted on 04 May 2017 A study led by Keele University, in collaboration with the Universities of Aberdeen and Manchester, shows that men and women suffering from heart failure have a higher risk of death than people with most common types of cancer.
Climate Politics in Interesting Times
Posted on 05 October 2017 Keele University has welcomed climate experts to an environment politics event to discuss the future of climate politics
The difficulties of translating Ian McEwan's books to the screen
Posted on 03 October 2017 This year three of his stories are being adapted for viewers
Professor Robert Sneyd visits his ancestral family home at Keele
Posted on 29 September 2017 Professor Robert Sneyd, Dean of the Plymouth University Peninsula Schools of Medicine and Dentistry, has recently visited the Sneyds’ ancestral family home at Keele Hall.
Keele Professor awarded Royal Academy of Engineering Fellowship
Posted on 08 September 2017 Professor Alicia El Haj FREng, FRSB has been elected as a Fellow of the Royal Academy of Engineering
Undocumented youth divided over how to fight back against Trump immigration clampdown
Posted on 24 August 2017 Ala Sirriyeh, Lecturer in Sociology writes for The Conversation (UK)
Keele University to help develop a ‘research school’ to improve learning outcomes in Stoke-on-Trent
Posted on 19 July 2017 Keele University is working to establish a ‘research school’ in Stoke-on-Trent, which aims to pilot innovative ideas for improving young people's learning and achievements.
School of Life Sciences welcomes new professor
Posted on 18 July 2017 Toby Bruce, Professor of Insect Chemical Ecology, has joined Keele University’s School of Life Sciences this month.
Keele signs MoU with Universiti Sains Malaysia
Posted on 17 July 2017 Keele University and Universiti Sains Malaysia (USM) have signed an agreement to foster collaborative work and research between the two institutions.
Honorary Graduates Datuk Professor Dr Asma Ismail, PhD and Ros Kerslake, OBE
Posted on 14 July 2017 In recognition of their outstanding contributions to society, both globally and within the UK, Datuk Professor Dr Asma Ismail, PhD and Ros Kerslake OBE have been awarded Honorary Degrees.
New laboratory research points way to how statins could be more effective in treatment of ovarian cancer
Posted on 14 July 2017 A new study led by Keele University has shown how statins may be used as a potentially effective treatment against ovarian cancer.
Honorary Graduates Anthony Berry MBE and Dr Michael Fisher
Posted on 11 July 2017 In recognition of their outstanding contributions to Keele University and the local area, Anthony Berry MBE and Dr Michael Fisher have been awarded Honorary Degrees.
Why are companies choosing to steer clear of public markets?
Posted on 04 July 2017 The number of firms choosing to list their shares on UK stock markets hit a decade-long low in 2016.
Keele University joins Midlands Innovation
Posted on 20 June 2017 Keele University is joining Midlands Innovation, one of the region’s most influential academic collaborations.
Keele signs collaboration agreement with University of Liverpool
Posted on 16 June 2017 Keele University and the University of Liverpool have signed an agreement to foster collaborative work and provision of cutting-edge technology access between the two institutions.
Keele announces honorary degrees for 2017
Posted on 15 June 2017 Six distinguished individuals from the fields of sport, medicine, education, business and philanthropy will be awarded honorary degrees at Keele during the University’s graduation ceremonies in July.
How a hung parliament totally changes the game for Brexit
Posted on 09 June 2017 Dr Helen Parr, Senior Lecturer in School of Politics, Philosophy, International Relations and Environment, writes for The Conversation UK
Ever thought a loved one was an imposter? That's the Capgras delusion
Posted on 08 June 2017 Professor Nicola Edelstyn writes for The Conversation UK
Keele invites high school and sixth form pupils to experience campus life
Posted on 13 June 2017 Keele University is inviting students to enjoy a taste of campus life this June and July, to experience what’s it’s like to study a subject and live in university halls.
From shouting it out to staying at home: a brief history of British voting
Posted on 06 June 2017 Emeritus Professor of French History at Keele University writes for The Conversation UK.
Debt bondage, domestic servitude and indentured labour still a problem in the world's richest nations
Posted on 26 May 2017 Dr Deirdre McKay writes for The Conversation UK
Planning permission approved for Smart Innovation Hub
Posted on 24 May 2017 This will be the first innovation centre in the UK to bring together a university management school and incubation space for innovative new and developing businesses.
Edward Hopper: the artist that evoked urban loneliness and disappointment with beautiful clarity
Posted on 18 May 2017 Dr James Peacock, Senior Lecturer in English and American Literatures, writes for The Conversation UK.
Keele No.1 in UK for Health Professions
Posted on 16 May 2017 Keele University is the number one institution in the UK to study Health Professions, according to the Guardian University Guide 2018.
International team wins £1m research grant
Posted on 12 May 2017Keele University is part of an international collaboration which has received a prestigious research grant for imaging single molecules.

Erdoğan ‘won’ his referendum, but what does that mean for Turkey’s foreign policy?
Posted on 09 May 2017 Researcher and PhD Candidate Salih Dogan writes for The Conversation UK.
Grand Challenges Lecture - 10th May
Posted on 05 May 2017 Professor Sally Wheeler - Global Business and the Challenge of Human Rights
Hard Evidence: does a lower pound boost manufacturing?
Posted on 05 May 2017 Dr Gabriella Legrenzi writes for The Conversation UK
New research finds swearing can make you stronger
Posted on 05 May 2017 Research presented by Keele’s Dr Richard Stephens at the British Psychological Society’s Annual Conference shows that swearing aloud can make you stronger.
Keele degrees accredited by Royal Society of Biology
Posted on 03 May 2017 The School of Life Sciences at Keele University has been awarded accreditation status by the Royal Society of Biology
Keele maintains national top ten position
Posted on 29 April 2017 Keele University has been ranked in the top ten of the national Times Higher Education (THE) Student Experience Survey for the second year running.
Keele joins forces with Well pharmacy to support its students
Posted on 27 April 2017 Keele University has announced a long-term partnership with the UK’s largest independent pharmacy chain, Well, to further enhance learning and professional development opportunities for those studying at its School of Pharmacy.
Forensic Science at Keele ranked No.1 in the UK
Posted on 26 April 2017 Keele University has been named the number one institution in the UK to study Forensic Science
Using pictures to explore the biological world
Posted on 24 April 2017 Professor Melissa Mather's forthcoming Inaugural Lecture looks at Innovative technologies for Biological Imaging
Can we trust the opinion polls in election 2017?
Posted on 24 April 2017 Dr Matthew Wyman writes for The Conversation UK: are opinion polls worth the paper they’re written on?
Government’s leading health adviser visits Keele University
Posted on 21 April 2017 Keele welcomed Professor Chris Whitty, the Chief Scientific Adviser for the Department of Health, to the School of Medicine recently.
Keele University celebrates academic promotions
Posted on 30 March 2017 Keele announces the most recent academic promotions
Keele Library ranked No. 1 in the UK
Posted on 23 April 2017 Keele University came joint first in the Times Higher Education (THE) Student Experience Survey for its ‘Good library and library opening times’, out of all 117 UK universities.
Keele’s IT Services reach final three at top national awards
Posted on 04 April 2017 Congratulations to the IT Service Desk team who reached the finals of the IT Service and Support Awards recently.
Keele top-rated in four key areas in largest global university ranking
Posted on 30 March 2017 Keele has been ranked in the top category across four key performance indicators in the 2017 U-Multirank global university ranking.
The Brexit divorce bill explained
Posted on 29 March 2017 Dr Christopher Huggins, Teaching Fellow in European Politics, writes for The Conversation UK after Prime Minister Theresa May triggered Brexit's Article 50.
Keele University appoints industry leaders to drive business innovation
Posted on 22 March 2017 The appointments will allow the University to continue to strengthen its commitment to underpinning its role as an important economic anchor across and beyond the region.
Major investment approved for Keele University campus
Posted on 22 March 2017 £160m development will transform student accommodation on campus, and provide a major boost to the local region
CSI Stoke: The Science of the Great War
Posted on 21 March 2017 An interactive day of science, history and discovery at The Potteries Museum and Art Gallery on Saturday 1st April
Keele top-rated in four key areas in Whatuni awards
Posted on 07 April 2017 Keele has been ranked in the top ten of four categories at the Whatuni Student Choice Awards 2017.
Research reveals how family history can affect your memory of hangovers
Posted on 20 March 2017 New research led by Psychologist Dr Richard Stephens explores the hangover frequency and severity of people with a family history of alcoholism.
Keele Language Centre helps refugees and asylum seekers learn English
Posted on 17 March 2017 Keele Language Centre has helped more than 200 refugees and asylum seekers whilst working with local charity.
Keele University awarded HEFCE Catalyst Funding
Posted on 17 March 2017 Keele University has been successful in its recent application for a HEFCE Catalyst grant.
Grand Challenges Lecture Series - 22nd March
Posted on 15 March 2017 Professor Richard Collier presents the next Grand Challenges Lecture, which asks the Law's 'Man Question'
The science 'reproducibility crisis' – and what can be done about it
Posted on 15 March 2017 Dr Jim Grange, Senior Lecturer in Psychology, writes for The Conversation UK.
First-of-its-kind trial at Keele University shows promising results
Posted on 13 March 2017 STEMS trial shows promising results for giving patients direct access to physiotherapy
Come on, Mr Trump – you can’t claim credit for another president’s successes
Posted on 10 March 2017 Gabriella Legrenzi, Senior lecturer in economics, writes for The Conversation UK.
Institute welcomes first visiting Fellows
Posted on 09 March 2017 The Institute of Liberal Arts and Sciences awards first four Fellowships
Countess of Wessex visits Keele University
Posted on 09 March 2017 Her Royal Highness The Countess of Wessex visited the North Staffs Asperger and Autism Association
School of Law climbs into global top 300
Posted on 08 March 2017 The School of Law has been ranked amongst the world’s top academic departments in the latest QS World University Subject Rankings.
Keele alumnus helps NASA discover seven new planets
Posted on 03 March 2017 Keele University Astrophysics graduate Dr Dan Holdsworth recently worked with NASA to observe a new solar system.
Meet Me at Live Age: ‘Celebrating Age’ Funding Success
Posted on 03 March 2017 New Vic Theatre and Keele University have secured £99,975 from Arts Council England’s and the Baring Foundation’s National Lottery-funded Celebrating Age programme
White Water Writers Book Launch
Posted on 02 March 2017 Children from Watermill School have written and published their own book under the supervision of a team from Keele University.
March - Arts Keele What's On
Posted on 01 March 2017 As we welcome lighter nights and warmer weather, Arts Keele has a full programme of events to see us through to spring.
Celebrating International Women's Day at Keele
Posted on 28 February 2017 Keele is celebrating International Women’s Day with a series of talks from inspiring women who have all excelled in their field.
Broken families: what happens to couples torn apart by immigration rules
Posted on 27 February 2017 Ala Sirriyeh, Lecturer in Sociology, writes for The Conversation UK
Digital toolkit aims to prevent falls amongst the elderly
Posted on 23 February 2017 The National Institute for Health and Care Excellence (NICE) has endorsed a new online toolkit developed by researchers at Keele University.
Study reveals pre-eclampsia increases risk of heart disease in later life
Posted on 21 February 2017 Research found women who suffered pre-eclampsia are four times more likely to have heart failure in later life.
The science of saying sorry
Posted on 21 February 2017 Dr Richard Stephens, Senior Lecturer in Psychology, writes for The Conversation UK
Six reasons to back the Stoke-on-Trent City Of Culture Bid
Posted on 16 February 2017 In the first of this series of articles supporting the bid, we outline six reasons to back Stoke-on-Trent for City of Culture in 2021.
Higher Horizons+ raising students' aspirations
Posted on 16 February 2017 Following its official launch, Higher Horizons+ has continued its energetic and dynamic approach to raising aspirations through engaging outreach activities.
The Shannon Matthews story: when personal tragedy becomes public spectacle
Posted on 14 February 2017 Siobhan Holohan writes for The Conversation UK about the recent BBC Drama series The Moorside.
Grand Challenges Lecture Series - 1st March
Posted on 14 February 2017 Professor Hinchliffe presents the next Grand Challenges lecture, which explores how we can co-exist with pathogenic microbes.
New research demonstrates a link between swearing fluency and emotion
Posted on 10 February 2017 Keele University psychologist Dr Richard Stephens has published a new research paper which explores how emotion impacts swearing.
Article 50 vote shows Brexit is about politics, not Britain's future
Posted on 09 February 2017 Dr Helen Parr writes for The Conversation UK about the latest Brexit development
Keele plays leading part in innovative stroke research breakthrough
Posted on 08 February 2017 Professor Christine Roffe is leading groundbreaking clinical trials into a smart chip that could save lives.
From Marx to Marketing
Posted on 07 February 2017 A forthcoming lecture by Professor Adrian Palmer will critically explore the role of free markets in our society.
February - Arts Keele What's On
Posted on 07 February 2017 Brighten a winter’s day with one of the many concerts, performances and events happening at Keele.
Higher Horizons+ is off to a flying start
Posted on 06 February 2017 The Keele University led Higher Horizons+ project, which aims to inspire young people from economically disadvantaged areas to enter Higher Education, has officially launched.
Film premiere puts culture at Keele on the big screen
Posted on 06 February 2017 A film celebrating the lives of two of Britain’s most iconic post-war designers has been premiered at Keele University.
Think swearing isn't big or clever? Think again!
Posted on 01 February 2017 Dr Richard Stephens, Senior Lecturer in Psychology, writes for The Conversation UK about his research into swearing.
Grand Challenges Lecture - 8 February
Posted on 31 January 2017 Professor Alison Phipps explores the question of what we can learn from the lives of refugees through the lens of arts and of language.
Keele backs City of Culture bid
Posted on 30 January 2017 Keele University is proud to support Stoke-on-Trent’s bid to be the official City of Culture 2021.
Winter Graduation 2017
Posted on 25 January 2017 Watch Keele University's Winter Graduation video with hundreds raising their caps in celebration with their friends and family.
Family celebrates double success at Keele graduation
Posted on 24 January 2017 A mother and daughter graduate together at Keele University
#spicerfacts: how the White House’s relationship with the press will play out
Posted on 24 January 2017 Politics lecturer Dr Jon Herbert writes for The Conversation UK about the first press conference of the Trump Presidency
What a child's humour reveals about their psychological well-being
Posted on 24 January 2017 Keele University's Dr Claire Fox writes for The Conversation UK about the link between a child's humour style and their mental health.
Keele secures part in €9.5 million food safety research project
Posted on 20 January 2017 Keele University sociologist Dr Lydia Martens is taking a leading part in a prestigious food safety collaborative programme.
ILAS PostGrad Conference: Connecting and constructing across the disciplines
Posted on 20 January 2017 Postgraduate students are invited to present at the second Institute of Liberal Arts and Science Postgraduate Conference.
Documentary celebrates the lives of two design icons
Posted on 18 January 2017 Members of the public are invited to Keele University for the premiere of a new film which documents the creative lives of two of Britain’s most prolific post-war designers.
Pests, pathogens and unpredictable rainfall: Global challenges for sustainable food production
Posted on 17 January 2017 Professor Sue Hartley explores the inter-disciplinary approaches which may provide new sustainable methods of crop protection and improved resilience to climate change
Keep Calm and Study On
Posted on 11 January 2017 Keele University students are being offered a range of activities to help them stay calm and keep healthy during the January exam period..jpg)
£70m Keele Deal to create 700 jobs in the region
Posted on 10 January 2017 700 jobs to be created and over 1,000 businesses supported as a result of a £70m research-led collaboration.
Alumna awarded OBE in New Year's Honours list
Posted on 09 January 2017 Keele alumna, Lynn Saunders, has been awarded an OBE in the New Year Honours list for public and voluntary services to prisoners in the UK and abroad.
Brexit, comedy and ‘Britishness’
Posted on 05 January 2017 Keele University's Neil Archer writes for The Conversation UK, about what to do when parody becomes real
Talented student brightens up children's A&E room
Posted on 04 January 2017 History and Sociology student Victoria Jenkinson has transformed a children’s room at the Royal Shrewsbury Hospital (RSH) into a colourful animal kingdom
Keele campus ranked 1st in the world for its green setting in league table
Posted on 04 January 2017 Keele University has been ranked the No.1 university in the world for its green setting and campus infrastructure.
Dave Emley awarded British Empire Medal
Posted on 31 December 2016 Former Keele geology technician awarded the British Empire Medal in the New Year Honours list
Dr Julie Hulme awarded a National Teaching Fellowship
Posted on 09 December 2016 Dr Hulme has been awarded the most prestigious award for teaching excellence in higher education
Keele to lead scheme inspiring more young people to enter HE
Posted on 08 December 2016 Keele University announces Higher Horizons+ National Collaborative Outreach Programme.
Keele University Announce Infrastructure Partnership to Support Growth Plans
Posted on 06 December 2016 Keele University has announced a long-term partnership with University Partnerships Programme (UPP) to deliver its ambitious enhancement and expansion project, delivering new and improved student accommodation to support its growth strategy.
HEFCE Catalyst bid success for Keele University
Posted on 05 December 2016 Keele University has been successful with its two bids to the HEFCE Catalyst fund to support two new learning and teaching projects for undergraduate and postgraduate students.
Keele University partners in £7m ‘green gas’ project
Posted on 30 November 2016 Keele University is set to be part of a ground-breaking programme to demonstrate the use of blended hydrogen - a ‘green’ gas - in the national gas grid.
Innovation in Teaching Politics Award for Keele's Dr Matthew Wyman
Posted on 29 November 2016 Keele University's Dr Matthew Wyman has won the presitigious Innovation in Teaching Politics Award at the Political Studies Association annual awards
Our Lives as Art - New Vic Theatre
Posted on 24 November 2016 New Vic Theatre's Ages & Stages Theatre company explores creativity in later life, as part of the Back to the Drawing Board exhibition series
Grand Challenges with Jonathon Porritt - Timeframe dilemmas: Why today’s sustainability narrative isn’t working
Posted on 23 November 2016 The Grand Challenges lecture series is delighted to welcome its next speaker, Keele University Chancellor Jonathon Porritt
Keele ranked No.1 for Student Satisfaction
Posted on 10 August 2016 Keele University has been ranked first for student satisfaction in the National Student Survey (NSS) for the third year running.
Keele University wins global award for student induction experience
Posted on 14 June 2017 Keele’s online induction for students has won a 2017 Blackboard Catalyst Award for optimising student experience.
School of Law celebrate 50th anniversary
Posted on 24 May 2017 Over 100 guests attended a Gala weekend to celebrate 50 years of law at Keele.
Keele University marks Refugee Week
Posted on 16 June 2017 Keele University is hosting a range of events to mark national Refugee Week 2017.
Keele students care for the sick on pilgrimage
Posted on 07 June 2017 Keele students and lecturers from the School of Nursing and Midwifery travelled with sick people on a pilgrimage to France recently.
Alumnus and foreign ambassador presents guest lecture
Posted on 31 January 2017 The Republic of Guinea’s Ambassador to the UK visited Keele University last week - 25 years after he left as a graduating student.
Professor David Amigoni to chair Stoke-on-Trent’s Cultural Forum
Posted on 31 May 2017 Professor David Amigoni, Pro-Vice Chancellor for Research and Enterprise at Keele University, has been invited to chair Stoke-on-Trent’s Cultural Forum.
Ancient DNA reveals how cats conquered the world
Posted on 21 June 2017 Janet Hoole, Lecturer in Biology, writes for The Conversation.
Keele holds one of the oldest children’s books known in existence
Posted on 02 March 2017 A 17th century children’s book A Guide to the Childe and Youth, published 42 years before any other known surviving copy, is held at Keele University Library.
Æthelflæd: the Anglo-Saxon iron lady
Posted on 21 June 2017 History lecturers Dr Philip Morgan and Dr Andrew Sargent, writes for The Conversation
Keele signs Technician Commitment
Posted on 31 May 2017 Keele is one of more than 35 universities and research institutions from across the UK which have today backed a pledge to support their technicians.
Keele ranked in Global Top 100 "Golden Age" universities
Posted on 10 April 2017 Keele University has been ranked amongst the best universities in the world in a new table focused on institutions founded in the aftermath of the Second World War.
Gayle Newland and the problem of equating ignorance with non-consent
Posted on 04 July 2017 Professor Alex Sharpe, from the School of Law, writes for The Conversation.
Keele University affirms commitment to high-quality partnerships in China
Posted on 22 June 2017 Keele University welcomed two high-level delegations from Chinese partners to Keele last week to enable future collaboration.
Keele University celebrates academic promotions
Posted on 23 February 2017 Congratulations to the following members of staff who have recently received esteemed promotions within their schools.
Celebrating long service staff members
Posted on 02 June 2017 The Vice-Chancellor recently hosted two dinners to commemorate Keele's longest-serving staff members, who between them have worked at Keele for over 350 years.
Keele celebrates long service members of staff
Posted on 22 June 2017 The Vice Chancellor Trevor McMillan and the executive team held a lunchtime reception last week to celebrate with twenty members of staff who have worked at Keele for twenty-five years or more.
Keele Excellence Awards 2017
Posted on 23 June 2017 Keele University is delighted to announce the Keele Excellence Award winners for 2016/17
World-leading climate change scientist to join Keele University
Posted on 12 April 2017 Professor Chris Fogwill, a leader in climate change research, has been announced as the new Head of School for Geography, Geology and the Environment.
Keele ranked joint first in the UK for ‘good support and welfare’
Posted on 12 May 2017 Keele University came joint first in the Times Higher Education (THE) Student Experience Survey for its ‘Good support and welfare’.
Keele University Professor appointed as new chair of Pharmacy Schools Council
Posted on 19 December 2016 Professor Nigel Ratcliffe has been announced as the new Chair of the Pharmacy Schools Council

